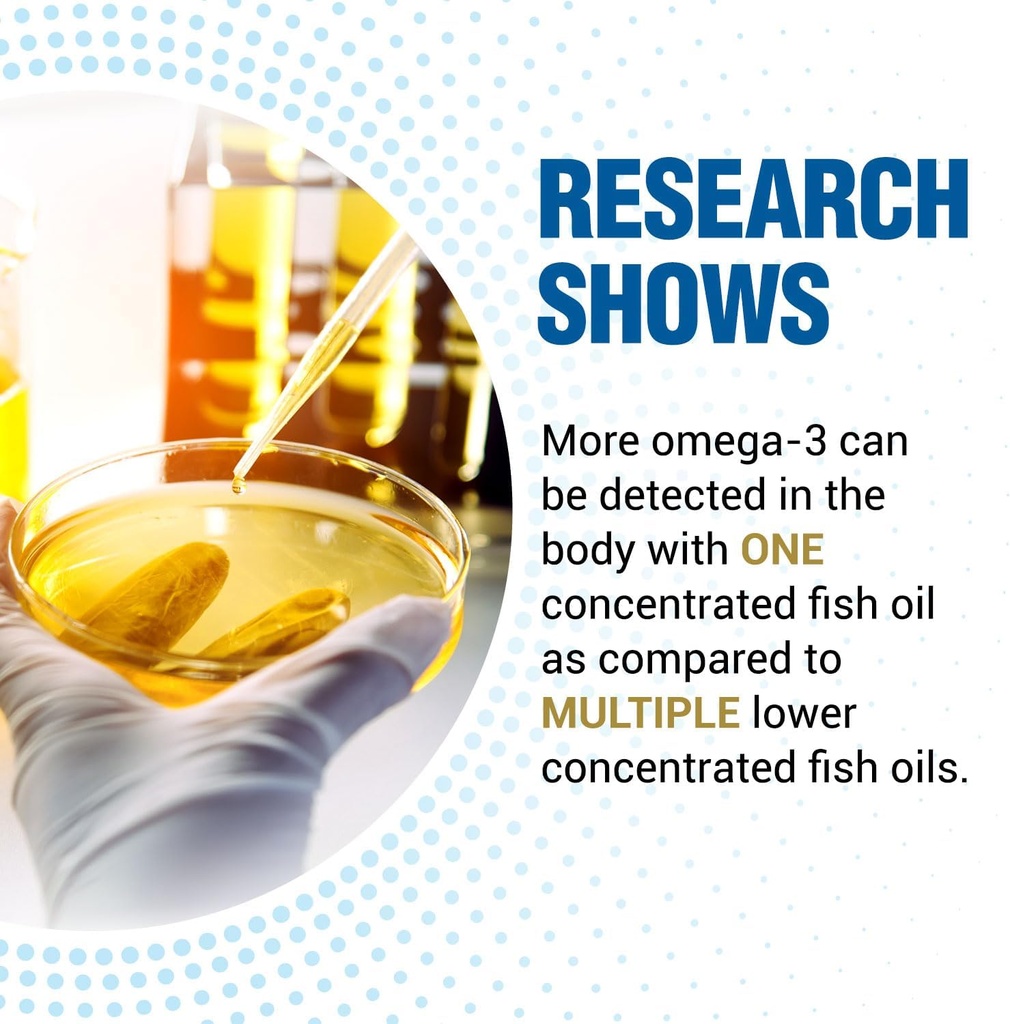
LABO Nutrition OmaxPure Omega3 Fish Oil - 1125mg Omega 3 IFOS Certified - High Potency rTG Omega Fish Oil Supplement with DHA & EPA - 120 Softgels 6

LABO Nutrition OmaxPure Omega3 Fish Oil - 1125mg Omega 3 IFOS certificado - alta potencia rTG Omega Fish Oil Suplemento con DHA & EPA - 120 Softgels
- UNA SOFTGEL DIA: Cada porción contiene 1.200 mg de aceite de pescado con 1,125 mg de ácidos grasos Omega-3 (764 mg EPA, 256 mg DHA, 30 mg DPA ácido graso). Proporciona una dosis diaria recomendada de Omega-3 para la salud general.
- SUPPORTS OVERALL HEALTH: Research shows that the essential fatty acids EPA & DHA in omega-3 fish oil help support heart, brain, eye and immune health.
- NO FISHY BURPS OR AFTERTASTE, ULTRA-FRESH: Utilizando la extracción de CO2 Supercrítica de un proceso de purificación de 3 capas, nuestro suplemento de aceite de pescado omega-3 es altamente puro, sin olor y burpless. Es superior a la destilación molecular y se purifica a temperaturas mínimas para eliminar metales pesados, mercurio, PCB y toxinas.
- OMAXFRESH TECHNOLOGY: Ensures maximal potency & freshness of the omega-3, keeping it as fresh as Day 1 throughout its shelf life while ensuring optimal absorption and bioavailability in the intestine.
- ULTRA-CONCENTRATED RTG OMEGA-3: 90% ultra-concentrado Triglyceride re-esterificado (rTG) forma de Omega-3, que es idéntico a la forma natural triglicérida pero más estable que el aceite de pescado Omega-3 de ester de etilo para una mejor absorción y biodisponibilidad.
- OMEGA 3 IFOS CERTIFIED FISH OIL: Nuestro aceite de pescado certificado Omega 3 IFOS es fuente de pescado de aguas profundas silvestres y experimenta rigurosas pruebas de terceros para cumplir con los estándares de aceite de pescado de omega 3 certificados IFOS para pureza, potencia y transparencia. Hecho en Japón, GMP certificado, no GMO, sin gluten y libre de aditivos artificiales.
- FORTIFIED CON ANTIOXIDANT: Una mezcla sinérgica de vitamina E natural y extracto romero protege los ácidos grasos omega-3 de la oxidación y la rancidez, garantizando la frescura y eficacia duraderas.
| Fecha de expulsión | Apr 2027 |
-
Obtén un 5% de descuento al comprar 4 o más artículos
-
Obtén un 5% de descuento en tu próxima compra.
-
Los pedidos se procesan y envían desde Brooklyn, EE. UU.
-
Disfrutá de envío gratis en pedidos superiores a AR$ 290,000.
3–6 días (Nacional).
Garantía de Devolución de 30 Días
Compras respaldadas por confianza con soporte de devolución de 30 días.
SKU |
BRSWYFT2PMFWCG36 |
Buy LABO Nutrition OmaxPure Omega3 Fish Oil - 1125mg Omega 3 IFOS Certified - High Potency rTG Omega Fish Oil Supplement with DHA & EPA - 120 Softgels on Amazon.com ✓ FREE SHIPPING on qualified orders
Shipping & Delivery
At Nutricity, we aim to deliver your order as quickly and safely as possible.
Domestic Shipping :
Orders are typically delivered within 3–6 business days.
International Shipping:
Estimated delivery time is 12–26 business days, depending on the destination and customs processing.
You will receive a tracking number once your order has been dispatched. Delivery times may vary during holidays or due to unforeseen delays.